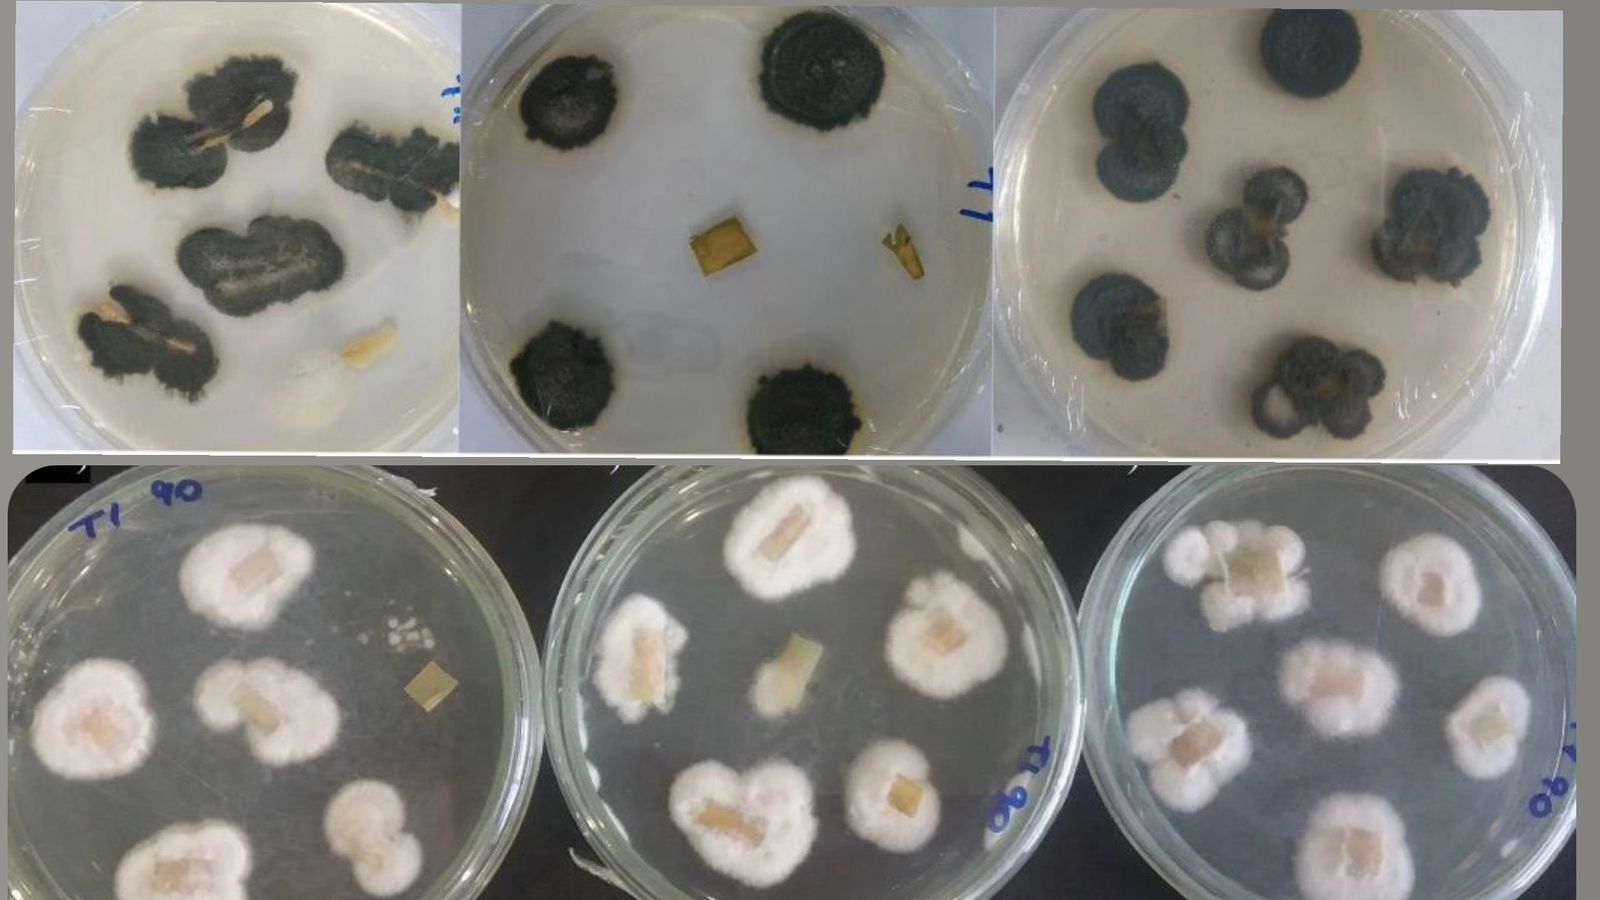

Controle da lagarta-do-cartucho: tecnologia com fungos endofíticos é destaque no estande da Fapema na AgroBalsas
A lagarta-do-cartucho (Spodoptera frugiperda) é um dos maiores pesadelos dos produtores de milho no Brasil. Essa praga voraz causa perdas milionárias ao atacar as plantações, e o combate tradicional, com inseticidas químicos e milho Bt, está se tornando cada vez menos eficaz. Mas uma pesquisa da professora Daiana Gomes, do Centro Universitário de Balsas (Unibalsas), pode trazer a solução para esse problema. O estudo, apresentado no estande da Fundação de Amparo à Pesquisa e ao Desenvolvimento Cientifico e Tecnológico do Maranhão (Fapema), na AgroBalsas, propõe o uso de fungos endofíticos como um novo método de controle biológico da lagarta-do-cartucho.
Estes fungos podem ajudar a reduzir o impacto ambiental da agricultura, proteger a saúde humana e garantir a segurança alimentar. O projeto tem o apoio da Fapema, por meio do edital Centelha II, que é fruto de parceria da Fundação com a Financiadora de Estudos e Projetos (Finep).
A pesquisadora explica que esses fungos vivem dentro das plantas e são capazes de matar as lagartas ao se alimentarem de seus tecidos. “A grande vantagem dessa abordagem é que os fungos ficam protegidos dentro da planta, o que os torna mais resistentes aos fatores abióticos, que podem inviabilizar outros métodos de controle biológico”, diz Daina Gomes.
Ela destaca que o controle da lagarta-do-cartucho enfrenta três grandes desafios: inseticidas químicos que não atingem o alvo e com isso a praga se torna mais resistente; o milho transgênico Bt que está começando a perder sua eficiência devido à resistência de algumas desta pragas; e o controle biológico pouco eficiente, por conta de fatores abióticos.
“O uso de fungos endofíticos como método de controle biológico, que estamos estudando, surge como solução promissora para esses desafios. Os fungos, protegidos dentro da planta, são menos suscetíveis ao desenvolvimento de resistência e a fatores abióticos que afetam outros métodos de controle”, observou Diana Gomes.
Os testes estão sendo feitos em laboratório e em campo. A pesquisadora acredita que essa tecnologia pode ser uma ferramenta importante para o manejo integrado da praga, reduzindo a necessidade de uso de inseticidas químicos.
“A apresentação do estudo no estande da Fapema, na AgroBalsas, foi uma oportunidade para divulgar essa pesquisa inovadora a um público amplo de produtores, técnicos e pesquisadores”, disse o diretor Administrativo da Fapema, Arnodson Campelo.
A feira, que se encerra neste sábado (18), é um importante espaço para o debate de novas tecnologias e soluções para os desafios da agricultura brasileira.